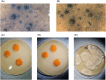

Biodiversity of microorganisms in the Baltic Sea: the power of novel methods in the identification of marine microbes
- PMID: 39366767
- PMCID: PMC11500664
- DOI: 10.1093/femsre/fuae024
Biodiversity of microorganisms in the Baltic Sea: the power of novel methods in the identification of marine microbes
Erratum in
-
Correction to: Biodiversity of microorganisms in the Baltic Sea: the power of novel methods in the identification of marine microbes.FEMS Microbiol Rev. 2025 Jan 14;49:fuaf002. doi: 10.1093/femsre/fuaf002. FEMS Microbiol Rev. 2025. PMID: 39847071 Free PMC article.
Abstract
Until recently, the data on the diversity of the entire microbial community from the Baltic Sea were relatively rare and very scarce. However, modern molecular methods have provided new insights into this field with interesting results. They can be summarized as follows. (i) Although low salinity causes a reduction in the biodiversity of multicellular species relative to the populations of the North-East Atlantic, no such reduction occurs in bacterial diversity. (ii) Among cyanobacteria, the picocyanobacterial group dominates when considering gene abundance, while filamentous cyanobacteria dominate in means of biomass. (iii) The diversity of diatoms and dinoflagellates is significantly larger than described a few decades ago; however, molecular studies on these groups are still scarce. (iv) Knowledge gaps in other protistan communities are evident. (v) Salinity is the main limiting parameter of pelagic fungal community composition, while the benthic fungal diversity is shaped by water depth, salinity, and sediment C and N availability. (vi) Bacteriophages are the predominant group of viruses, while among viruses infecting eukaryotic hosts, Phycodnaviridae are the most abundant; the Baltic Sea virome is contaminated with viruses originating from urban and/or industrial habitats. These features make the Baltic Sea microbiome specific and unique among other marine environments.
Keywords: Baltic Sea; diversity of microorganisms; marine ecosystem; marine viruses; molecular methods; prokaryotic and eukaryotic microorganisms.
© The Author(s) 2024. Published by Oxford University Press on behalf of FEMS.
Conflict of interest statement
The authors declare no conflict of interest.
Figures

References
-
- Aevarsson A, Kaczorowska AK, Adalsteinsson BT et al. Going to extremes—a metagenomic journey into the dark matter of life. FEMS Microbiol Lett. 2021;368:fnab067. - PubMed
-
- Ahrens R, Moll G. Ein neues knospendes bakterium aus der Ostsee. (A new budding bacterium from the Baltic Sea). Archiv Mikrobiol. 1970;70:243–65. - PubMed
Publication types
MeSH terms
Grants and funding
LinkOut - more resources
Full Text Sources